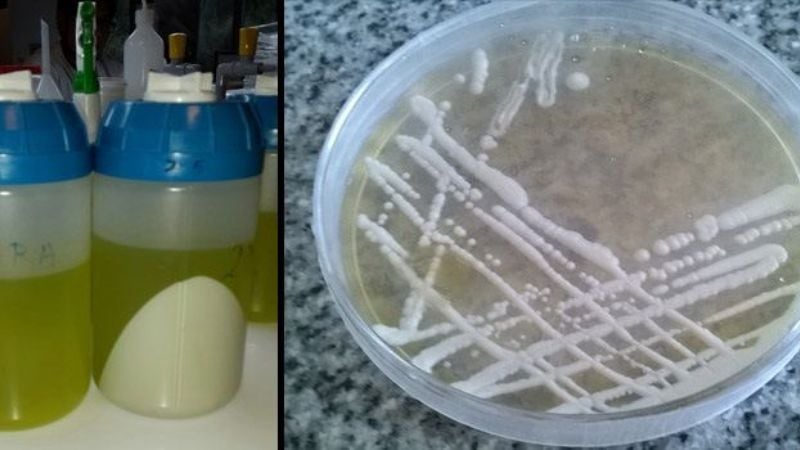
Diseñan una nueva vacuna para combatir la Hepatitis B

Según datos de la Organización Mundial de la Salud, desde el
año 1982 la población dispone de una vacuna contra la Hepatitis B (HBV) con una
eficacia del 95 por ciento. Sin embargo, recientes estudios publicados en
revistas internacionales alertan sobre el surgimiento de nuevas cepas que
resisten a los tratamientos antirretrovirales que reciben los pacientes que
padecen el Virus de Inmunodeficiencia Humana (VIH).
Frente a esta problemática, el Instituto de Investigaciones
en Microbiología y Parasitología Médica de la Facultad de Medicina de la
Universidad de Buenos Aires conformó un equipo de expertos en bioquímica, biotecnología
y farmacéutica para buscar erradicar el virus de una de las enfermedades más
graves después que el Sida y la Tuberculosis, según la OMS.
"A partir del estudio en diversos pacientes se descubrió que
el virus de la Hepatitis B generaba un escape a la vacuna actualmente
comercializada en personas que padecen HIV y que están coinfectados con HBV y
reciben sus correspondientes tratamientos antirretrovirales duales”, reveló la
Dra. María Lujan Cuestas, bioquímica y especialista en enfermedades virales.
Y agregó: "Es decir, personas que presentaban una serología
positiva para el HIV y que además tenían el virus de la Hepatitis B dejaban de
responder a la terapia para la hepatitis B porque generaban mutantes que además
no serían protegidos con la vacuna anti-hepatitis B actual. Claramente, la
terapéutica entre HIV y HBV no es la misma, aunque hay compuestos que pueden
ser compartidos, como algunos análogos nuclesídicos o nucleotídicos”, manifestó
la experta.
En ese sentido, y dadas las similitudes entre ambas
enfermedades, su transmisión es similar: el contagio puede darse por vía sexual
(oral, anal y vaginal), a través de transfusiones de sangre o trasplantes de
órganos, por compartir agujas contaminadas (en el caso de usuarios que consumen
drogas ilícitas por vía endovenosa), y, también, de una madre a su bebé durante
el embarazo, nacimiento o lactancia.
La diferencia radica en el grado de infección. "Por ejemplo,
en un accidente de laboratorio, si uno se pincha con una aguja que conlleva
sangre contaminada, la persona tiene un 30 por ciento de infectarse con HBV y
un 3 por ciento de contraer HIV”, explicó la especialista.
Y, en ese sentido, agregó: "El problema mayor es cuando se
contrae Hepatitis B crónica ya que tiene como consecuencia la cirrosis hepática
y el cáncer de hígado. De hecho, el 80 por ciento de pacientes que tiene cáncer
de hígado presentan serología positiva para esta enfermedad”.
Replicación celular
Los virus son pequeños agentes infecciosos que dañan las
estructuras de las células y, mediante ellas, logran infectar al cuerpo humano
haciéndose de su maquinaria de reproducción para multiplicarse. Si el sistema
inmunológico del cuerpo está fortalecido, puede destruir el virus, de lo
contrario, comienza el proceso de infección. Para ello existen las vacunas que
aniquilan los virus que el propio cuerpo no puede destruir.
Ocurre, a veces, que, a pesar de estar vacunado, los virus
pueden inmunizarse a las vacunas. Por ello, es imperante mejorar los
inmunógenos, es decir, los componentes de las vacunas, para que esto no ocurra.
"En el caso de la Hepatitis B, los pacientes con HIV son los que presentan una
alta tasa de mutantes de escape a la vacuna anti-hepatitis B debido a las
mutantes del HBV seleccionadas durante las terapéutica antirretroviral”,
detalló Cuestas.
El primer tramo del proyecto esgrime la creación de una
vacuna específica para los que padecen HIV y, más adelante, la producción a
gran escala para el resto de la población, de acuerdo a lo establecido en el
Calendario Nacional de Vacunación. "El trabajo también comprende la idea de
hacer una vacuna que pueda ser administrada por la vía oral y/o transcutánea ya
que de esta forma la respuesta inmunológica es mucho mejor, más segura y
aceptada por el común de las personas”, adelantó la experta.
El trabajo consagró al equipo del Instituto UBA-CONICET como
ganadores del certamen UBATEC 2015, un certamen que fomenta y difunde el
conocimiento, experiencias e ideas innovadoras en el uso de las TIC para
facilitar su uso, con el objetivo de dar respuesta a las necesidades
productivas y sociales del país.
"Es por medio de este concurso que ahora estamos viendo la
posibilidad de asociarnos con una empresa nacional para ver si podemos trabajar
de manera conjunta para que se pueda llevar a cabo la exportación de este nuevo
producto”, contó Cuestas. Y finalizó: "De ser así, imaginamos que en dos o tres
años podemos finalizar con el proyecto, dado que ya contamos con todos los
inmunógenos desarrollados”.
Fuente: Agencia CTyS-UNLaM